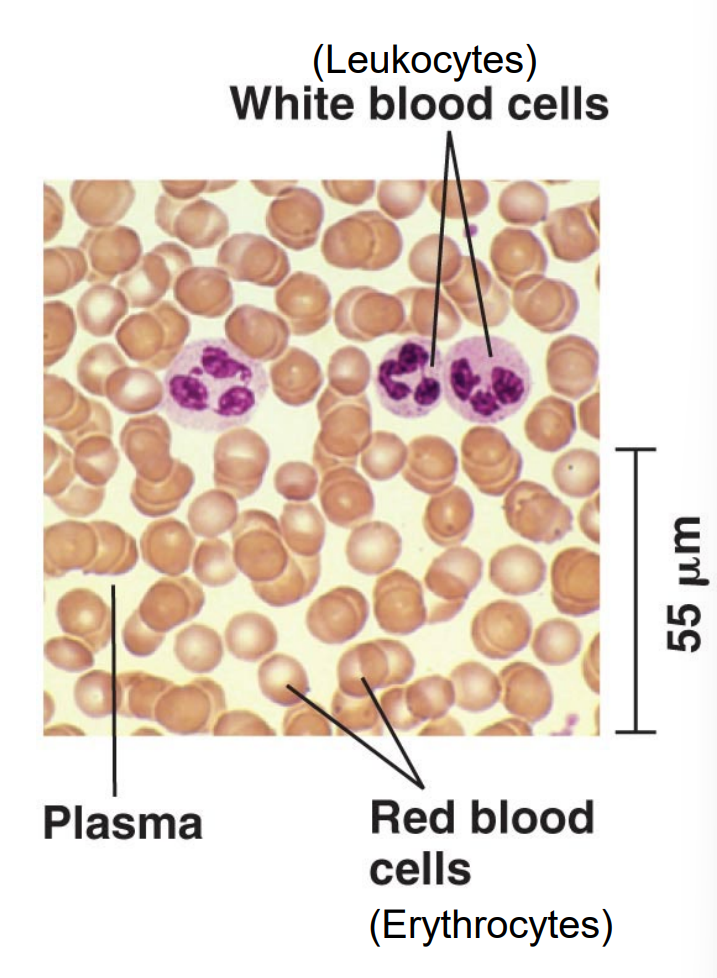
<p>A liquid connective tissue that transports oxygen, nutrients, wastes, and immune cells throughout the body; composed of blood plasma, erythrocytes, leukocytes, and platelets</p>

Lab 18: Histology
1/66
There's no tags or description
Looks like no tags are added yet.
Name | Mastery | Learn | Test | Matching | Spaced | Call with Kai |
|---|
No analytics yet
Send a link to your students to track their progress
67 Terms
histology
the microscopic study of animal cells and tissues; structure leads to function
cell
the basic structural and functional unit of all life
tissue
a collection of cells that have similar structures and functions
organ
a collection of different tissues working together for a specific function
Epithelial tissue
Tissue that covers internal and external body surfaces and functions in protection, absorption, and secretion.
ex. simple squamous, stratified squamous, simple cuboidal, simple columnar
found in digestive, respiratory, reproductive, circulatory, and integumentary systems
Apical surface
The exposed surface of epithelial tissue facing the body cavity, lumen, or external environment.
Basal surface
The bottom surface of epithelial cells that attaches to the basement membrane.
Basement membrane
A thin layer that anchors epithelial tissue to the underlying connective tissue.
Simple epithelium
A single layer of epithelial cells attached to the basement membrane.
Stratified epithelium
Multiple layers of epithelial cells stacked on top of each other; tissue named by shape of cell on apical surface
Squamous cells
Thin, flat epithelial cells specialized for diffusion and filtration.

Cuboidal cells
Cube-shaped epithelial cells specialized for secretion and absorption.

Columnar cells
Tall, column-shaped epithelial cells specialized for absorption and secretion.

frog kidney tubules
simple cuboidal epithelium rolled into a tube

simple cuboidal epithelium
specialized for secretion and absorption
frog intestinal lining
simple columnar epithelial cells; structured to maximize surface area for nutrient absorption
intestinal villi
finger-like projections of epithelial tissue into the intestinal lumen
microvilli
microscopic membrane protrusions from individual epithelial cells
Connective tissue
Tissue that supports, binds, protects, and connects other tissues in the body; internal transport, storage, and insulation
ex. adipose, blood, bone, dense fibrous, loose fibrous, hyaline cartilage
found in integumentary, circulatory, skeletal, musculoskeletal systems
Extracellular matrix
Nonliving material surrounding connective tissue cells that provides support and structure; network of proteins and minerals that may be liquid, semi-solid, or solid
Loose connective tissue
A connective tissue with loosely arranged thin mesh fibers that holds organs and tissues together.
Dense connective tissue
Connective tissue with densely packed collagen fibers that provides strong structural support; high tensile strength (resistant to stretching); includes ligaments and tendons
Ligaments
Dense connective tissue that connects bone to bone.
Tendons
Dense connective tissue that connects muscle to bone.
Cartilage
Flexible connective tissue that provides support and cushioning in structures like the nose, ears, and joints.

chondroitin sulfate
protein-carbohydrate complex that gives the cartilage a jelly-like consistency
Chondrocytes
Cells that produce and maintain cartilage.
Lacunae
Small spaces within the extracellular matrix that house cells such as chondrocytes and osteocytes.
bone
hard, mineralized connective tissue that comjprises the skeleton of vertebrate animals

Compact bone
Dense bone tissue that forms the hard outer layer of bones.

bone matrix
contains calcium, magnesium, and phosphate to make it solid
Osteocytes
bone cells
Haversian canal
central canal tubes in the osteon matrix for nerves and blood vessels to run through
Lamellae
Concentric layers of bone matrix surrounding the Haversian canal, arranged in concentric circles.
Canaliculi
Tiny thin channels in the matrix connecting lacunae and Haversian canal that allow nutrient and waste exchange between bone cells.
Osteon
The structural unit of compact bone consisting of a Haversian canal surrounded by lamellae.

Blood
A liquid connective tissue that transports oxygen, nutrients, wastes, and immune cells throughout the body; composed of blood plasma, erythrocytes, leukocytes, and platelets
Plasma
fluid matrix; the liquid component of blood that carries cells, nutrients, hormones, and waste products.
Erythrocytes
Red blood cells that carry oxygen using hemoglobin.
Leukocytes
White blood cells involved in immune defense.
Platelets
Cell fragments that help with blood clotting.
Adipose
Connective tissue specialized for fat storage, insulation, and cushioning.

Nervous tissue
Tissue specialized for communication through electrical and chemical signals; transmitting and receiving signals to control the body; collect sensory info, coordinate action, perform mental activity
composed of two classes of cells: neurons and glia
found in central and peripheral nervous systems
Neuron
A nerve cell that sends and receives electrochemical signals in the nervous system; consists of cell body/soma, axon, and dendrites
Cell body/soma
The part of a neuron containing the nucleus.
Axon
a long projection of a neuron that sends signals
Dendrites
Branched extensions of a neuron that receive signals.
Neural processes
Extensions of neurons including axons and dendrites.
Glial cells
provide structural and nutritional support to neurons
Muscle tissue
Tissue specialized for contraction in response to nerve signals to produce movement.
ex. skeletal, cardiac, smooth
found in musculoskeletal, cardiovascular, and digestive systems
Skeletal muscle
Striated voluntary muscle attached to bones that moves the skeleton.

Cardiac muscle
Striated involuntary muscle responsible for contraction of the heart.

Intercalated disc
Specialized junctions between cardiac muscle cells that allow rapid electrical communication.
Smooth muscle
Non-striated involuntary muscle found in internal organs and blood vessels.
Striations
Visible banding patterns in skeletal and cardiac muscle caused by organized contractile proteins.
Voluntary muscle
Muscle under conscious control, such as skeletal muscle.
Involuntary muscle
Muscle that contracts automatically without conscious control, such as cardiac and smooth muscle.
Skin
The largest organ of the body that protects against environmental damage and regulates temperature.
Epidermis
The outermost layer of skin made of stratified squamous epithelial tissue.
Dermis
The middle layer of skin containing connective tissue, glands, blood vessels, and nerves.
Hypodermis
The deepest layer of skin composed mainly of adipose tissue for insulation and energy storage.
Keratinized layer
A tough, protective outer layer of dead cells in the epidermis filled with keratin.
Sebaceous glands
Oil-producing glands in the skin that secrete sebum to lubricate hair and skin.
Sweat glands
Glands that produce sweat to regulate body temperature.
Chromatophores
Pigment-containing cells that give color to frog skin.
Mucus glands
Glands in frog skin that secrete mucus to keep the skin moist.
Poison gland
Specialized gland in frog skin that secretes toxins for defense.